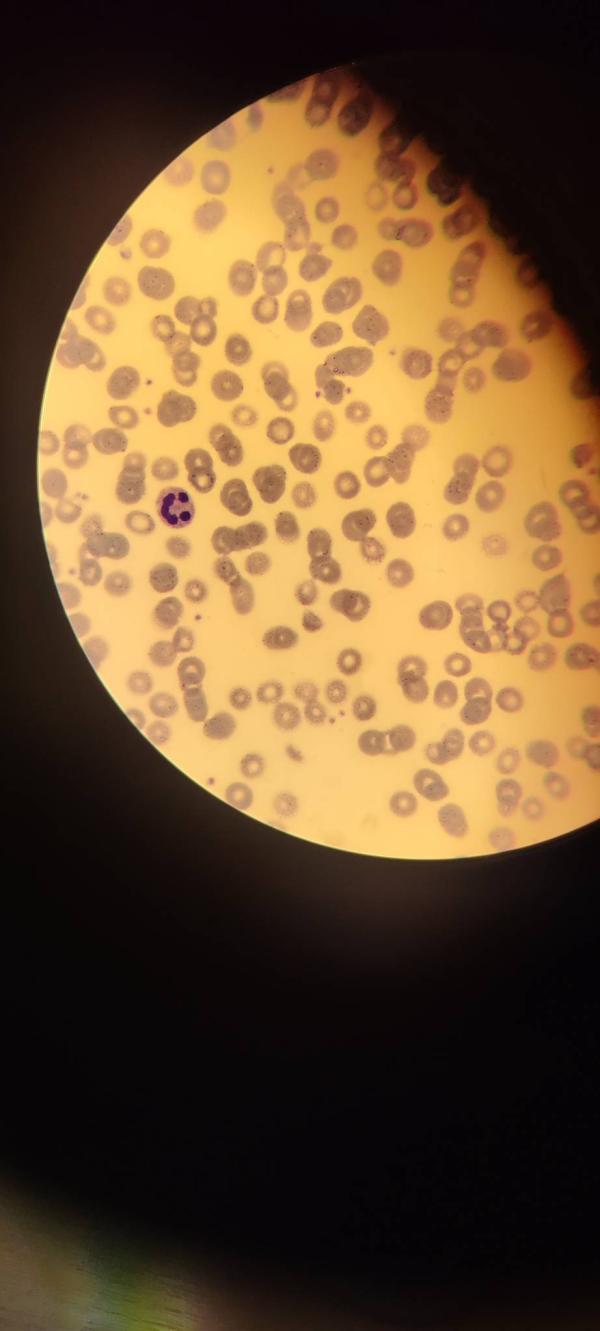
post image

🔬 Микроскопия: мир, где даже клетки улыбаются! 😊
Знаете ли вы, что под микроскопом скрывается целая вселенная, полная удивительных форм и красок? А иногда там можно встретить и по-настоящему "улыбающиеся" клетки! 😍
Это фото — не фотошоп, а реальный снимок. Природа и наука не перестают удивлять!
Кто сказал, что наука — это скучно? Здесь есть место и чуду, и даже юмору. ✨
#Микроскопия #НаукаЭтоКрасиво #УлыбнисьКакКлетка


